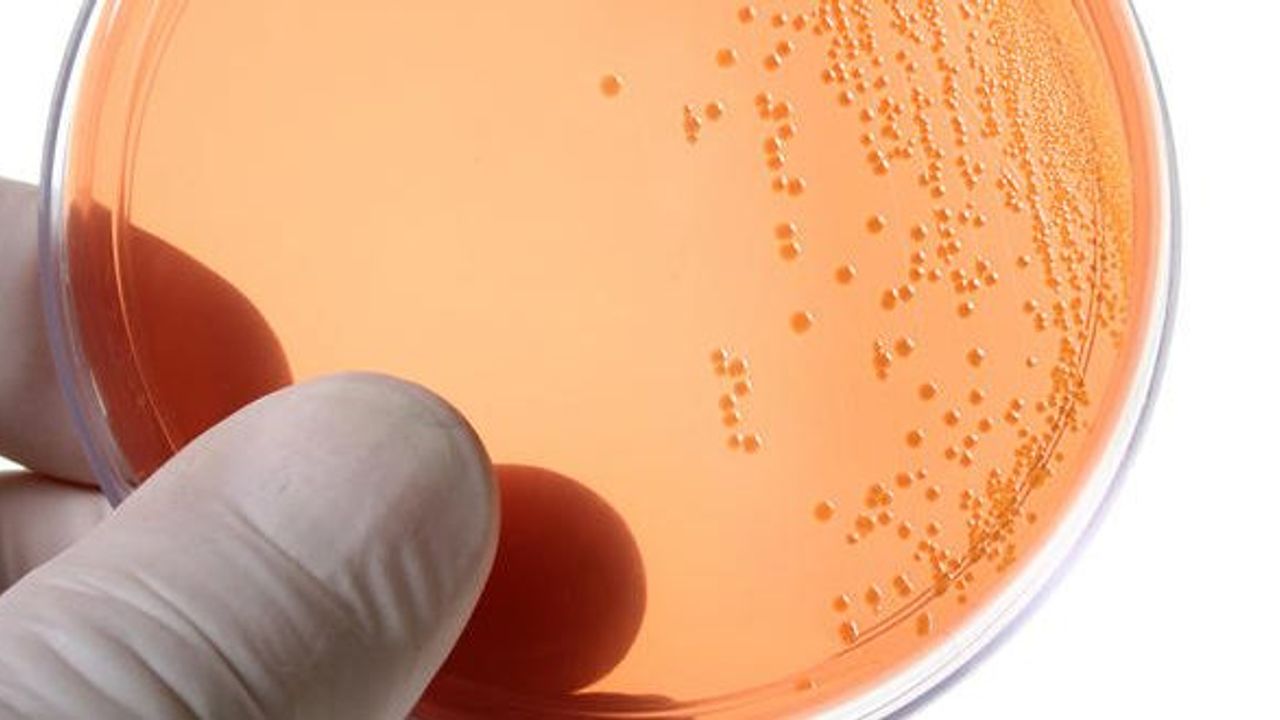

Klamidya, cinsel yolla bulaşan yaygın bir hastalıktır . Chlamydia trachomatis adı verilen bakterilerden kaynaklanır. Hem erkeklere hem de kadınlara bulaşabilir. Kadınlar serviks, rektum veya boğazda klamidya alabilirler. Erkekler üretrada (penisin içinde), rektumda veya boğazda klamidya olabilir. Peki Klamidya belirtileri nelerdir?
KLAMİDYA NEDİR?
Bakteriyel bir enfeksiyon hastalığı olarak kabul edilen klamidya oldukça ciddi bir rahatsızlık olup ihmale gelmemesi gerekir. Düzenli olarak doktor kontrolünün yapılması gerekirken erkek ve kadınlarda farklı tepkiler ortaya koymaktadır. Bazen kişiler bu hastalığın belirtilerini gözle görüp hissedebilirken bazen ise hiçbir şikayet hissetmez ve bu enfeksiyonu istemeden partnerine de bulaştırabilir.
KLAMİDYA BELİRTİLERİ NELERDİR?
Kadın ve erkeklerde farklı şekilde gözlenebilen ve belirtiler veren klamidyanın kadınlardaki belirtileri;
1.Yoğun miktarda ve kötü kokulu olabilen vajinal akıntı
2.Ağrılı adet kanamaları
3.Adet zamanları arasında görülen kanamalar
4.Vajina etrafındaki bölgede kaşıntı ya da yanma
5.Cinsel ilişki sırasında ağrı
6.İdrar yaparken ağrı şeklinde görülebilir
Klamidyanın erkeklerdeki belirtileri;
1.Ağrılı idrara çıkma
2.Penis ucunun çevresinde yanma ve kaşıntı
3.Penis ucunun çevresinde yanma ve kaşıntı
4.Testis çevresinde ağrı ve şişlik